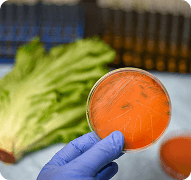
Food Inspection of Cap Enclosure

Our Computer Vision Development Services
Transform visual data into informed decisions with our computer vision development services, which automate visual analysis and deliver actionable insights instantly.

Intelligent object tracking and detection
Gain insights from videos and images – ideal for virtual try-ons, visual search, and medical scans, as well as automating smart labeling.

Visual search-powered recommendations
Enhance user engagement with personalized suggestions and offers by utilizing AI-powered product recognition and intelligent visual similarity.

AI-powered visual quality analysis
Automate defect checks on cargo and product lines using intelligent visual systems, reducing errors from manual checks and improving accuracy.

Automated Data Extraction and OCR
Digitize and generate data from documents by leveraging OCR solutions, engineered to automate complex processing tasks, forms, and paperwork.

AI-Based Pose Tracking
Analyze human movement for interactive systems, security, and fitness with real-time activity interpretation and real-time pose tracking.

Intelligent video analytics and surveillance
Detect suspicious activities in real-time by leveraging video analysis. This technology is ideal for monitoring and detecting violence, as well as automating monitoring systems.
Join the league of satisfied clients who are scaling with Proquantic’s AI-powered solutions.
Empowering Leading Industries with Computer Vision Solutions
From healthcare to manufacturing, Proquantic’s custom Computer Vision development services and solutions empower industries to see, analyze, and innovate smarter.

Computer Vision Software Development Cost Calculator
Are you curious to know how much it will cost you? Get a ballpark figure for your big idea. For everything else, we are a call away!
Our Technology Stack
Proquantic Software is your trusted software development company with an in-house vetted pool of top-tier industry talent synonymous with successful solutions across industries
Frequently Asked Questions (FAQs)
Answering your most common queries, helping you make informed decisions. For everything else, we're just a call away.


From 25 Reviews on Clutch